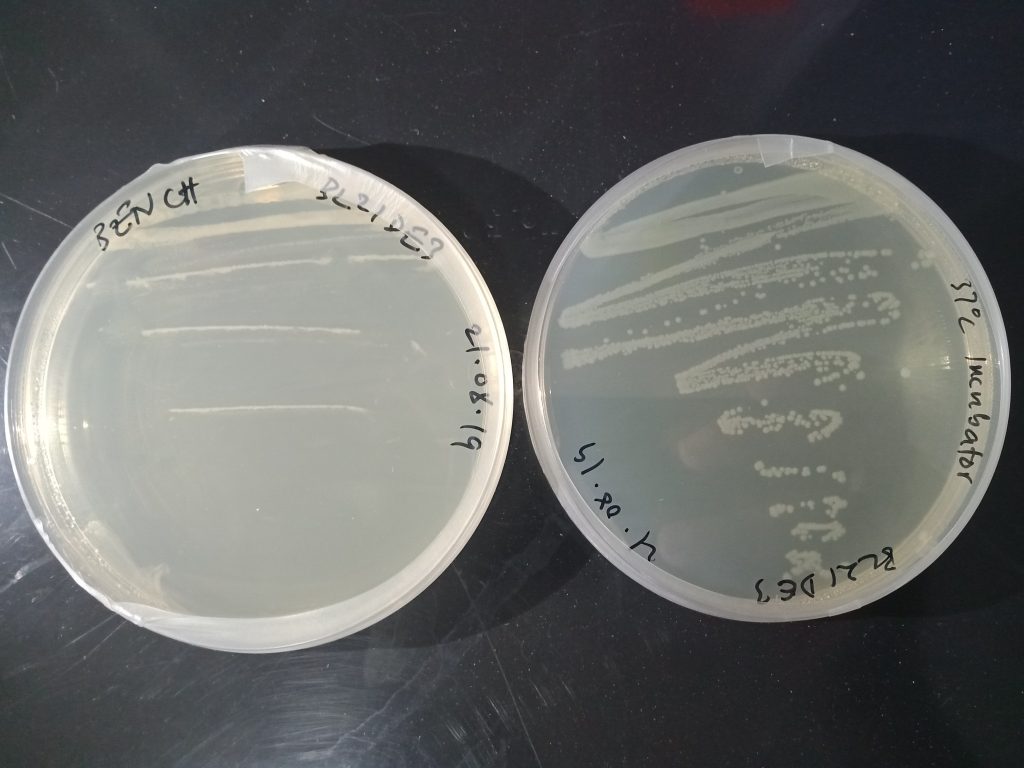

The Open Bioeconomy Lab Team at MboaLab in Cameroon were awarded a $750 grant by the Build Free and Open Science Hardware Project led by Andre Chagas and supported by the Mozilla Foundation to build a low-cost, open-source incubator for microbiology. Most biology labs in Cameroon and elsewhere in resource-constrained contexts are under-equipped due to the high cost of lab equipment and it is essential for many protocols including open enzyme manufacturing to have optimal growth temperature for important microrganisms such as Escherichia coli bacteria. We believe that DIY and Open Science Hardware can facilitate access to low-cost and high-quality equipment for biology labs in Cameroon, Ghana and beyond.
All resources are openly licensed and linked below. Future plans include the inclusion of orbital shaking which increases aeration of cultures and therefore the yield of micro-organisms and their products like proteins.
Related Links
- Documentation of Hive BioLab build on Benchling
- Documentation of Hive BioLab build on WikiFactory
Acknowledgements
- Ongola FabLab and OER Cameroon Team: Ariel Kameni and Yves Obame
- Kumasi Hive Makerspace Team: Evans Tetteh-Djangbah and Isaac Atia-Abugbilla
- Image credits for Incubator: MboaLab Team
- GFP E.coli image in header: DanceWithNyanko on Wikimedia Commons. Licensed under CC-BY-SA 4.0